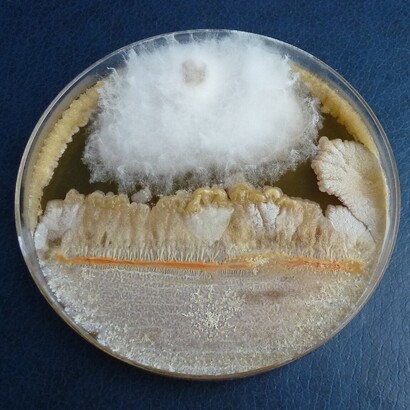
Il Fusarium venenatum rappresenta un esempio innovativo di biotecnologia applicata all’alimentazione. Coltura del microfungo Fusarium
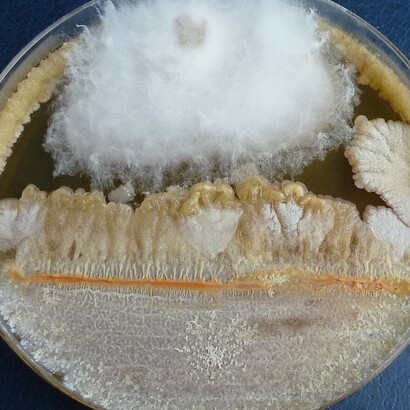
Viene impiegato come ingrediente in alimenti destinati a diete vegetariane e vegane. Coltura del microfungo Fusarium
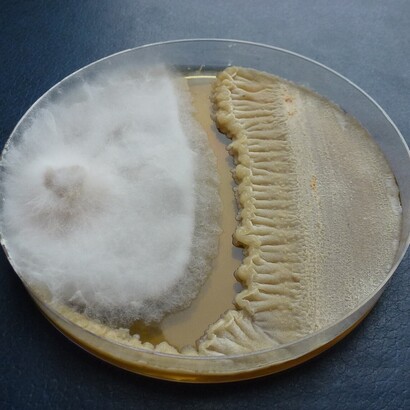
Il suo utilizzo è regolamentato e sottoposto a rigorosi controlli di sicurezza alimentare. Coltura del microfungo Fusarium

Un articolo pubblicato sulla rivista Trends in Biotechnology riporta i risultati di modifiche genetiche effettuate su funghi della specie Fusarium venenatum per renderli più digeribili come cibo e la loro coltivazione più sostenibile. Un team di ricercatori ha utilizzato la tecnica per le modifiche genetiche chiamata CRISPR/Cas9 per ottenere un ceppo di Fusarium venenatum che può essere considerato migliorato senza aggiungere geni di altri organismi ma limitandosi a eliminare due geni presenti in natura in questo fungo.
La specie Fusarium venenatum è già utilizzata da tempo come alternativa alla carne in tante ricette vegetariane e vegane. Il ceppo designato come FCPD dovrebbe rendere più facile la sua produzione proprio per le minori risorse necessarie e più attraente per il pubblico grazie a una maggior digeribilità. Per i creatori del ceppo FCPD si tratta di una strategia che ha il potenziale per essere estesa ad altri modelli alternativi di produzione di fonti proteiche da usare come cibo.
Il Fusarium venenatum è un microfungo, un tipo di fungo costituito da una struttura microscopica di produzione delle spore e quindi invisibile a occhio nudo. Lieviti e muffe sono conosciuti da tempo immemorabile mentre altri microfunghi che sono stati identificati in tempi più o meno recenti possono essere patogeni come la famigerata Candida ma anche utili in medicina come la penicillina.
Per il suo elevato contenuto di proteine, il Fusarium venenatum ha attirato l'attenzione fin dalla sua scoperta, avvenuta nel 1967, proprio come potenziale sostituto della carne. Era un periodo in cui il tema della sovrappopolazione, con il problema di nutrire la quantità crescente di persone, stava diventando importante al punto da stimolare la ricerca di nuove fonti di cibo.
In realtà, sembra che il Fusarium venenatum si sia diffuso soprattutto come ingrediente di ricette vegetariane e vegane in varie nazioni in cui è stato approvato per il consumo umano. Per consistenza e sapore, è probabilmente il fungo che maggiormente si avvicina alla carne, perciò ha il potenziale per attirare chi vorrebbe almeno limitarne il consumo.
Purtroppo il Fusarium venenatum ha due difetti non da poco: non è facile da digerire a causa della chitina presente nelle sue pareti cellulari e richiede parecchie risorse per essere prodotto. Le colture di questo microfungo sono costituite da vasche riempite di sciroppo di glucosio arricchite di ossigeno e di minerali necessari al suo sviluppo.
Gli autori di questo studio hanno cercato il modo di creare un ceppo di Fusarium venenatum che mantenesse i suoi pregi eliminandone i difetti. Per ottenerlo hanno utilizzato la tecnica genetica chiamata CRISPR/Cas9, una delle tecniche della famiglia CRISPR (Clustered Regularly Interspaced Short Palindromic Repeats) che utilizza l'enzima Cas9 guidato da uno specifico RNA per modificare il gene selezionato.
Ci sono sempre controversie quando si parla di OGM, soprattutto quando questi organismi geneticamente modificati includono geni provenienti da altre specie, a volte appartenenti a gruppi molto diversi. È un argomento complesso con varie ramificazioni che sono state sviluppate nel corso degli anni. In questo caso, i ricercatori non hanno aggiunto geni estranei ma si sono limitati a eliminare due geni che causano i difetti di questo microfungo per produrre il ceppo denominato FCPD.
Il primo gene eliminato è quello che serve a sintetizzare la chitina della parete cellulare e la sua eliminazione ha reso più sottile tale parete, rendendo le proteine nelle cellule di questi microfunghi più facilmente digeribili. Il secondo gene eliminato è legato al metabolismo di questi funghi e la sua eliminazione limita le risorse necessarie a produrre le proteine buone come cibo per gli umani, quasi dimezzando la quantità di glucosio necessaria.
Per capire meglio l'impatto della produzione del ceppo FCPD del Fusarium venenatum, i ricercatori ne hanno simulato le varie fasi in sei diverse nazioni. La scelta è dovuta al fatto che queste nazioni vanno dalla Finlandia, che utilizza soprattutto energie rinnovabili, alla Cina, che utilizza ancora molto il carbone. In tutti i casi, il ceppo FCPD permette una diminuzione delle emissioni di gas serra del 60% nel corso del suo ciclo vitale.
La sostenibilità della produzione del ceppo FCPD del Fusarium venenatum è perfino superiore quando viene paragonata alle risorse necessarie alla produzione di proteine animali. Ad esempio, le simulazioni indicano una riduzione del 70% delle emissioni rispetto alla produzione di pollo in Cina.
La popolazione mondiale continua ad aumentare e l'allevamento di animali sta diventando sempre più difficilmente sostenibile, soprattutto quello di bovini, che richiede tra le altre cose enormi quantità di terreni per coltivare il loro cibo. Le proteine micobiche, cioè quelle prodotte da funghi, potrebbero rappresentare più che mai una soluzione e questo studio mostra come sia possibile migliorare la qualità di un fungo che è già considerato tra le migliori alternative alla carne. Anche dal punto di vista etico, i vantaggi potrebbero superare le remore di chi normalmente si oppone agli OGM. Il lavoro condotto sul Fusarium venenatum potrebbe aprire la strada ad altre produzioni di fonti proteiche alternative molto utili per sfamare una popolazione sempre in crescita.